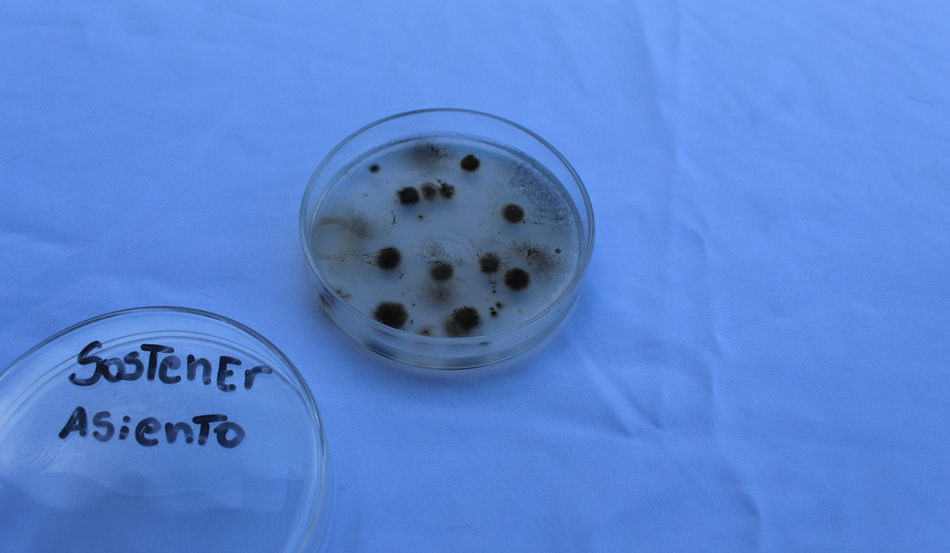
IMG_8094.jpg

ACTOS Y EVENTOS 2025
FERIA DE LA CIENCIA
![]() | ![]() | ![]() |
|---|---|---|
![]() | ![]() | ![]() |
![]() | ![]() | ![]() |
![]() | ![]() | ![]() |
![]() | ![]() | ![]() |
![]() |
OLIMPIADAS DEPORTIVAS PARTHENIANAS




ANIVERSARIO 21
![]() | ![]() | ![]() |
|---|---|---|
![]() | ![]() | ![]() |
![]() | ![]() | ![]() |
![]() | ![]() | ![]() |
DÍA DE LA CHILENIDAD
![]() | ![]() | ![]() |
|---|---|---|
![]() | ![]() | ![]() |
![]() | ![]() | ![]() |
![]() | ![]() | ![]() |
![]() | ![]() | ![]() |
SPELLING BEE AND TOURNAMENT HOUSES
![]() | ![]() | ![]() |
|---|---|---|
![]() | ![]() | ![]() |
![]() | ![]() | ![]() |
![]() | ![]() | ![]() |
![]() | ![]() | ![]() |
![]() | ![]() | ![]() |
FERIA VOCACIONAL 2025
![]() | ![]() | ![]() |
|---|---|---|
![]() | ![]() | ![]() |
![]() | ![]() | ![]() |
![]() | ![]() | ![]() |
![]() |
FERIA DE LA MATEMÁTICA
![]() | ![]() | ![]() |
|---|---|---|
![]() | ![]() | ![]() |
![]() | ![]() | ![]() |
![]() | ![]() | ![]() |
![]() | ![]() | ![]() |
![]() | ![]() |
![]() | ![]() | ![]() |
|---|---|---|
![]() | ![]() | ![]() |
![]() | ![]() | ![]() |
![]() | ![]() | ![]() |
![]() | ![]() | ![]() |
![]() | ![]() | ![]() |
![]() | ![]() | ![]() |
![]() | ![]() | ![]() |
![]() | ![]() | ![]() |
![]() | ![]() | ![]() |
![]() | ![]() | ![]() |
![]() | ![]() | ![]() |
![]() | ![]() | ![]() |
![]() | ![]() | ![]() |
![]() | ![]() | ![]() |
![]() | ![]() | ![]() |
![]() | ![]() | ![]() |
![]() | ![]() |
CELEBRACIÓN DÍA DEL ALUMNO 2025
El pasado viernes 16 de mayo se llevo a cabo una celebración muy especial, esta giro en torno a todos nuestros niños y niñas pues festejamos el día del alumno, esta celebración que se efectua por decreto 147 de la constitución politica de chile reunio a todos nuestros alumnos en torno a entretenidas activades como Zumba, show de freestyle, pinta carita, camara 360°, juegos inflable y de obstaculos, estas fueron preparadas por el equipo de convivencia y apoyadas por los docentes y directivos.
Agradecemos tambien al centro de padres por su apoyo en el kiosko de comida saludable.
Ademas se entrego un pequeño reconocimiento a los cursos con mayor votación en el museo de personajes literarios, y se presento a la lista de ganadores del centro de alumnos, lista A.
Disfruta de todos los videos en la sección de convivencia escolar y en nuestro instagram.
![]() | ![]() | ![]() |
|---|---|---|
![]() | ![]() | ![]() |
![]() | ![]() | ![]() |
![]() | ![]() | ![]() |
![]() | ![]() | ![]() |
![]() | ![]() | ![]() |
![]() | ![]() | ![]() |
![]() | ![]() | ![]() |
![]() | ![]() | ![]() |
![]() | ![]() | ![]() |
![]() | ![]() | ![]() |
![]() | ![]() | ![]() |
![]() | ![]() | ![]() |
![]() | ![]() | ![]() |
![]() | ![]() | ![]() |
![]() | ![]() | ![]() |
![]() | ![]() | ![]() |
![]() | ![]() | ![]() |
![]() | ![]() | ![]() |
![]() | ![]() | ![]() |
![]() | ![]() | ![]() |
![]() | ![]() |
MES DEL LIBRO
En el marco de la celebración del mes del libro, es un agrado para nosotros compartir con nuestra comunidad educativa todas las actividades.
Dimos inicio con la visita de la editorial ANTÜ, a quienes agradecemos enormemente por todo su apoyo y colaboración con nuestras actividades, en esta ocasión M Jose Domange y Rodrigo Elgueda estuvieron acompañados del joven artista Emilio Elgueda quien compartio con nuestros auditores el lanzamiento de su manga Dearfull Dream, Ademas todos pudieron disfrutar de un pequeño taller de ilustracion para comic dirigido por Rodrigo, quien gracias a su experiencia dio sabios consejos a los futuros ilustradores.
Ademas agardecemos la participación de los apoderados de 1° y 2° basico quienes iniciaron las intervenciones en sala, haciendo gala de su creatividad narraron cuentos infantiles a los alumnos.
Los más pequeños de nuestro colegio mostraron sus dotes artisticos mediante la narración de cuentos infantiles, agradecemos el apoyo de sus familias y el trabajo de las educadoras en conjunto con sus asistentes.
Y nuestro gran actividad de cierre el "Museo Partheniano de personajes literarios", trabajo realizado por alumnos de 6° a 3° medio, guiado por sus profesoras de lenguaje, todo esto acompañado de guias y cuentacuentos a cargo de alumnos de 4° medio A-B quienes mostraron tambien un gran trabajo y apoyo.
Agradecemos enormemente al departamento de lenguaje y al CRA por su gran labor, a los docentes de aisgnatura, apoderados y directivos por su apoyo por su durante esta celebración.
Dejamos algunas de las imagenes de estas maravillosas actividades.
DÍA DE LA CONVIVENCIA ESCOLAR
"La convivencia escolar se construye a través de las relaciones que se producen entre todas las personas que forman parte de la comunidad educativa. Será positiva si esta construcción se realiza desde el respeto, la aceptación de las diferencias y de las opiniones de todos en un plano de igualdad. Esta construcción debe favorecer la resolución de los posibles conflictos, desacuerdos, tensiones o disputas de manera pacífica".
¡Feliz día de la convivencia educativa en Parthenon College!.
El dia de hoy nuestro equipo de convivencia puso toda su creatividad para que los alumnos disfrutaran con actividades realizadas durante los recreos, espacios pensados para todos donde pudieron compartir y disfrutar junto a sus compañeros, amigos y profesores.
Encuentra videos en sección convivencia escolar.
![]() | ![]() | ![]() |
|---|---|---|
![]() | ![]() | ![]() |
![]() | ![]() | ![]() |
![]() | ![]() | ![]() |
![]() | ![]() | ![]() |
![]() | ![]() | ![]() |
![]() | ![]() | ![]() |
![]() | ![]() | ![]() |
![]() | ![]() | ![]() |
![]() | ![]() | ![]() |
![]() | ![]() | ![]() |
![]() | ![]() | ![]() |
![]() | ![]() | ![]() |
![]() | ![]() | ![]() |
![]() | ![]() | ![]() |
![]() | ![]() | ![]() |
![]() | ![]() | ![]() |
![]() | ![]() | ![]() |
![]() | ![]() | ![]() |
![]() | ![]() | ![]() |
![]() | ![]() | ![]() |
![]() | ![]() | ![]() |
DÍA DE LA ACTIVIDAD FISICA 2025
REVIVE LOS MEJORES MOMENTOS DE LA CELEBRACIÓN DEL DÍA DE LA ACTIVIDAD FÍSICA
![]() | ![]() | ![]() |
|---|---|---|
![]() | ![]() | ![]() |
![]() | ![]() | ![]() |
![]() | ![]() | ![]() |
![]() | ![]() | ![]() |
![]() | ![]() | ![]() |
![]() | ![]() | ![]() |
![]() | ![]() | ![]() |
![]() | ![]() | ![]() |
![]() | ![]() | ![]() |
![]() | ![]() | ![]() |
![]() | ![]() | ![]() |
![]() | ![]() | ![]() |
![]() | ![]() | ![]() |
![]() | ![]() | ![]() |
![]() | ![]() | ![]() |
![]() | ![]() | ![]() |
![]() | ![]() | ![]() |
![]() | ![]() | ![]() |
![]() | ![]() | ![]() |
![]() | ![]() | ![]() |
![]() | ![]() | ![]() |
![]() | ![]() | ![]() |
![]() | ![]() |
ACTOS Y EVENTOS 2024


Y día de la convivencia escolar




Visita de destacadas instituciones de educación superior



MES DEL LIBRO 2024
CERTIFICACIÓN 8° BASICO 2023
![]() | ![]() |
|---|---|
![]() | ![]() |
![]() | ![]() |
![]() | ![]() |
![]() | ![]() |
![]() | ![]() |
![]() | ![]() |
![]() | ![]() |
![]() | ![]() |
![]() | ![]() |
![]() | ![]() |
![]() | ![]() |
![]() | ![]() |
![]() | ![]() |
![]() | ![]() |
CERTIFICACIÓN KINDER 2023
![]() | ![]() | ![]() |
|---|---|---|
![]() | ![]() | ![]() |
![]() | ![]() | ![]() |
![]() | ![]() | ![]() |
![]() | ![]() | ![]() |
![]() | ![]() | ![]() |
![]() | ![]() | ![]() |
![]() | ![]() | ![]() |
![]() | ![]() | ![]() |
![]() | ![]() | ![]() |
![]() | ![]() | ![]() |
![]() | ![]() | ![]() |
![]() | ![]() | ![]() |
![]() | ![]() | ![]() |
![]() | ![]() | ![]() |
![]() | ![]() | ![]() |
![]() | ![]() | ![]() |
![]() | ![]() | ![]() |
![]() |
CEREMONIA PREMIACIÓN 2023
![]() | ![]() | ![]() |
|---|---|---|
![]() | ![]() | ![]() |
![]() | ![]() | ![]() |
![]() | ![]() | ![]() |
![]() | ![]() | ![]() |
![]() |
CEREMONIA PEQUEÑO LECTOR 2023
Lo alumnos de 1° básico mostraron sus habilidades lectoras en una emotiva ceremonia en la cual cada uno leyó un fragmento de un cuento infantil, felicitamos a las familias por este logro y los invitamos a seguir promoviendo la lectura recreativa.
![]() | ![]() | ![]() |
|---|---|---|
![]() |
CIERRE DE AÑO NAVIDEÑO PK Y KINDER
Con un emotivo concierto navideño los y las pequeñas de PK y K mostraron todas sus habilidades artísticas en el área de música y el ingles
![]() | ![]() |
|---|---|
![]() | ![]() |
![]() |
ANIVERSARIO 2023
![]() | ![]() | ![]() |
|---|---|---|
![]() | ![]() | ![]() |
![]() | ![]() | ![]() |
![]() | ![]() | ![]() |
![]() | ![]() | ![]() |
![]() | ![]() | ![]() |
![]() | ![]() | ![]() |
![]() | ![]() | ![]() |
![]() | ![]() | ![]() |
![]() | ![]() | ![]() |
FERIA CIENTÍFICA 2023
Para el presente año todos nuestros alumnos dieron vida un vez más a esta singular y entretenida actividad, además contamos con la visita de personal del SAG quienes dieron muestra de una gran exposición de insectos chilenos, agradecemos la colaboración y el gran trabajo de nuestros estudiantes y profesores y felicitamos a los ganadores.
![]() | ![]() | ![]() |
|---|---|---|
![]() | ![]() | ![]() |
![]() | ![]() | ![]() |
![]() | ![]() | ![]() |
![]() | ![]() | ![]() |
![]() | ![]() | ![]() |
![]() | ![]() | ![]() |
![]() | ![]() | ![]() |
![]() | ![]() | ![]() |
![]() | ![]() | ![]() |
![]() | ![]() | ![]() |
FIESTAS PATRIAS 2023
Para el presenta año la celebración de las fiesta patrias tuvo énfasis en canta autores y canta autoras de nuestro país, dejamos las mejores imágenes de esta gran celebración.

DÍA DE LAS MATEMÁTICAS 2023
Matemáticas recreativas, lúdica y entretenidas, así fueron las actividades realizadas por el departamento de matemáticas, desde PK a 4° medio, con las cuales todos los alumnos de nuestro colegio pudieron integrarse y aprender.
FERIA VOCACIONAL 2023
Agradecemos la gestión realizada por convivencia escolar, a la profesora Gloria Rojas, a las instituciones de educación superior asistentes, así como también a los colegios invitados y el interés de nuestros alumnos en esta 2da versión de la feria vocacional.
HOBBY FEST 2023
Con una propuesta diferente y entretenida los profesores Paulo Orellana y Nicolás Abarca implementaron con alumnos de 8° y 1° medio el primer Hobby Fest, reuniendo todo el talento y la creatividad, la música, el arte y la tecnología en un solo lugar.
CELEBRACIÓN DÍA DEL ALUMNO 2023
OLIMPIADAS DEPORTIVAS PARTHENIANAS 2023
Por 4rto año celebramos las olimpiadas deportivas, con el objetivo de brindar un espacio a todos nuestros niños para demostrar sus habilidades y aptitudes deportivas en diferentes disciplinas, para el presente año hemos querido dar inicio a esta actividad con un acto solemne en donde representantes de cada curso hicieron el juramento del deportista y el equipo de cheerleaders OLIMPOS hizo su primera presentación demostrando todo su talento.
El día jueves 4 de mayo dimos inicio a las competencias, los mas pequeñitos de nuestro colegio hicieron gala de toda su velocidad y agilidad en las pruebas atléticas, a pesar del frio presente en el estadio escolar se pudo llevar a cabo la actividad en compañía de profesores, asistentes de aula y apoderados, agradecemos a la municipalidad y a don Claudio Furio por todo su apoyo.
CELEBRANDO EL MES DEL LIBRO 2023
Agradecemos al comité organizador y a todos los alumnos y apoderados que participaron de esta gran celebración que año a año alcanza mayor trascendencia en nuestra comunidad, felicitamos a los ganadores y ganadoras esperando que sigan explotando todos sus talentos y aptitudes.
GRADUACIÓN 4° MEDIO 2022
GRADUACIÓN 8° 2022
CERTIFICACIÓN KINDER 2022
Premiación 2022
El esfuerzo, la disciplina, el compañerismo y las habilidades deportivas fueron reconocidas y premiadas.
ANIVERSARIO 2022
Nos hemos reencontrado para disfrutar de una sana convivencia escolar compartiendo y fortaleciendo los valores que día a día inculcamos en nuestros estudiantes.
Agradecemos a nuestro centro de alumnos y ex-alumnos por su colaboración como jueces en algunas actividades, a los alumnos de 4 medio A y B por apoyar en la preparación de materiales para las pruebas, a todos nuestros docentes que siempre están por y para sus alumnos, a centro padres y apoderados por el apoyo brindado a sus hijos y a convivencia escolar, con apoyo de dirección para poder gestar esta actividad.
DESPEDIDA 4tos MEDIOS 2022
El termino de una etapa ha llegado, y este lunes fue el turno de la onceava generación de 4° medio que hoy deja nuestro colegio, con un emotivo encuentro con sus seres queridos, hoy cierran un capitulo de su vida...muchos éxitos a todos, estamos orgullosos de ustedes y agradecemos el haber sido parte de su historia.
FESTIVAL DE LA VOZ 2022
La fundación CREAPRENDE en conjunto con nuestro colegio realizo el primer festival de la voz, alumnos de nuestro colegio y del Instituto Calera de Tango pudieron dar muestra de todo su talento .
FERIA CIENTÍFICA 2022
Agradecemos a los docentes que dieron apoyo a los estudiantes participantes, y felicitamos al grupo del curso ganador por su gran trabajo.
fiestas patrias 2022
!Celebremos todos juntos¡ el pasado lunes 12 de Septiembre nos hemos vuelto a reunir como la gran comunidad que somos, para celebrar nuestras fiestas patrias, agradecemos la colaboración de todos.
El día jueves 2 de junio se dio termino a la capacitación en reanimación y manejo de desfibrilador, logrando la certificación de varios de nuestros docentes, asistentes de aula e inspectores, agradecemos el apoyo del superintendente de Bomberos de nuestra comuna, Roberto Valenzuela.
pretendemos brindar mayor seguridad a todos nuestros niños y jóvenes.
Agradecemos de antemano todo el apoyo brindado por Bomberos y esperamos seguir realizando muchas mas actividades en conjunto.
Es un agrado para nosotros compartir con toda nuestra comunidad educativa, que todos nuestros docentes han participado durante el año 2022 en diferentes capacitaciones, relacionadas con evaluación y neurociencias aplicadas a la educación, además de charlas sobre manejo de niños con asperger a cargo de asperChile, mejorando y optimizando aún más nuestro quehacer docente, para entregar educación de calidad.



1ra Feria vocacional 2022
Es un agrado compartir con nuestra comunidad la realización de la primera feria vocacional, a la cual asistieron 15 universidades, e instituciones que brindaron información a nuestros estudiantes, además se conto con la visita de algunos colegios de la comuna, se agradece el esfuerzo y la gestión realizada por la profesora Gloria Rojas, el coordinador de convivencia escolar profesor David Iturra y el apoyo de directivos
2do SPELLING BEE PARTHENON 2022
OLIMPIADAS DEPORTIVAS PARTHENIANAS 2022
Inicio de clases 2022
![]() |
|---|
1er SPELLING BEE PARTHENON 2021
![]() | ![]() | ![]() |
|---|
Graduación 4° medio 2021
Despedida 4° medio 2021
REVIVE LOS MEJORES MOMENTOS DE LA MUESTRA MULTICULTURAL PARTHENON COLLEGE 2021
SEMANA DE LA CONVIVENCIA Y DIA DEL LIBRO 2021

Describe your image

Describe your image


Describe your image
celebración día del profesor 2020
SEMANADE LA CHILENIDAD PARTHENIANA 2020
SEMANA PARTHENIANA 2020
PREMIACIÓN 2019
![]() | ![]() |
|---|---|
![]() | ![]() |
![]() | ![]() |
![]() | ![]() |
![]() |

![IMG_20211207_095732[1]](https://static.wixstatic.com/media/f5f4f3_a61360eb79fb44bdb429cb572c6a0234~mv2.jpg/v1/fill/w_250,h_187,al_c,q_90,enc_auto/f5f4f3_a61360eb79fb44bdb429cb572c6a0234~mv2.jpg)
![IMG_20211207_095726[1]](https://static.wixstatic.com/media/f5f4f3_c0978576c0ea4af5a989a1d4a0bdac92~mv2.jpg/v1/fill/w_250,h_187,al_c,q_90,enc_auto/f5f4f3_c0978576c0ea4af5a989a1d4a0bdac92~mv2.jpg)

![IMG_20211203_121759[1]_edited.jpg](https://static.wixstatic.com/media/f5f4f3_a8ba6e8c930d42779c40c2b741976b02~mv2.jpg/v1/fill/w_770,h_398,q_90,usm_5.80_0.74_0.17,enc_avif,quality_auto/f5f4f3_a8ba6e8c930d42779c40c2b741976b02~mv2.jpg)
![IMG_20211203_121730[1].jpg](https://static.wixstatic.com/media/f5f4f3_1d8be3cd68774c0b92a47bcd287a4ff0~mv2.jpg/v1/fill/w_940,h_398,q_90,enc_avif,quality_auto/f5f4f3_1d8be3cd68774c0b92a47bcd287a4ff0~mv2.jpg)
![IMG_20211203_121826[1].jpg](https://static.wixstatic.com/media/f5f4f3_a86e2f72508d428cb294abb9d88dc003~mv2.jpg/v1/fill/w_940,h_398,q_90,enc_avif,quality_auto/f5f4f3_a86e2f72508d428cb294abb9d88dc003~mv2.jpg)
![IMG_20211203_123110[1].jpg](https://static.wixstatic.com/media/f5f4f3_dc1e1f64efba4ed3903180fff7ec5840~mv2.jpg/v1/fill/w_940,h_398,fp_0.37_0.27,q_90,enc_avif,quality_auto/f5f4f3_dc1e1f64efba4ed3903180fff7ec5840~mv2.jpg)
![IMG_20211203_123627[1].jpg](https://static.wixstatic.com/media/f5f4f3_c3ef3ac9eb794510a44f85fca3c8bd56~mv2.jpg/v1/fill/w_940,h_398,fp_0.53_0.33,q_90,enc_avif,quality_auto/f5f4f3_c3ef3ac9eb794510a44f85fca3c8bd56~mv2.jpg)
![IMG_20211203_124430[1].jpg](https://static.wixstatic.com/media/f5f4f3_9417ef0698464ac5a0576e1925d927f0~mv2.jpg/v1/fill/w_940,h_398,fp_0.45_0.35,q_90,usm_29.20_0.00_0.00,enc_avif,quality_auto/f5f4f3_9417ef0698464ac5a0576e1925d927f0~mv2.jpg)
![IMG_20211203_125912[1].jpg](https://static.wixstatic.com/media/f5f4f3_8058418b7a144bc8821f51b7ef492fd0~mv2.jpg/v1/fill/w_940,h_398,q_90,usm_5.80_0.74_0.17,enc_avif,quality_auto/f5f4f3_8058418b7a144bc8821f51b7ef492fd0~mv2.jpg)
![IMG_20211203_130151[1].jpg](https://static.wixstatic.com/media/f5f4f3_8e5bf9f8be8c4dc9a4beb3094f8d505a~mv2.jpg/v1/fill/w_940,h_398,fp_0.37_0.4,q_90,enc_avif,quality_auto/f5f4f3_8e5bf9f8be8c4dc9a4beb3094f8d505a~mv2.jpg)
![IMG_20211203_130246[1].jpg](https://static.wixstatic.com/media/f5f4f3_577f90c5ef0c437fa1e0ed2a7e5ee769~mv2.jpg/v1/fill/w_940,h_398,fp_0.25_0.39,q_90,usm_5.80_0.74_0.17,enc_avif,quality_auto/f5f4f3_577f90c5ef0c437fa1e0ed2a7e5ee769~mv2.jpg)
![IMG_20211203_130346[1].jpg](https://static.wixstatic.com/media/f5f4f3_2e62a0b183bc46d6b7e3034aa0046ab6~mv2.jpg/v1/fill/w_940,h_398,fp_0.51_0.31,q_90,enc_avif,quality_auto/f5f4f3_2e62a0b183bc46d6b7e3034aa0046ab6~mv2.jpg)
![IMG_20211203_130609[1].jpg](https://static.wixstatic.com/media/f5f4f3_dcf75ab3207f4a77ae0abe09866f4b01~mv2.jpg/v1/fill/w_940,h_398,fp_0.55_0.2,q_90,usm_5.80_0.74_0.17,enc_avif,quality_auto/f5f4f3_dcf75ab3207f4a77ae0abe09866f4b01~mv2.jpg)
![IMG_20211203_131447[1].jpg](https://static.wixstatic.com/media/f5f4f3_7db07f0d173a4f8692e719adf5622c79~mv2.jpg/v1/fill/w_940,h_398,fp_0.4_0.3,q_90,enc_avif,quality_auto/f5f4f3_7db07f0d173a4f8692e719adf5622c79~mv2.jpg)
![IMG_20211203_132107[1].jpg](https://static.wixstatic.com/media/f5f4f3_993589c388ff469799fc8962dbab6b90~mv2.jpg/v1/fill/w_940,h_398,fp_0.49_0.37,q_90,enc_avif,quality_auto/f5f4f3_993589c388ff469799fc8962dbab6b90~mv2.jpg)
![IMG_20211203_132404[1].jpg](https://static.wixstatic.com/media/f5f4f3_715dc9b5004d4849b96686a6f0fed4ea~mv2.jpg/v1/fill/w_940,h_398,fp_0.45_0.33,q_90,enc_avif,quality_auto/f5f4f3_715dc9b5004d4849b96686a6f0fed4ea~mv2.jpg)
![IMG_20211203_132534[1].jpg](https://static.wixstatic.com/media/f5f4f3_6190e7057cdf4f9ea286ac876beb15f5~mv2.jpg/v1/fill/w_940,h_398,fp_0.4_0.36,q_90,enc_avif,quality_auto/f5f4f3_6190e7057cdf4f9ea286ac876beb15f5~mv2.jpg)
![IMG_20211203_132649[1].jpg](https://static.wixstatic.com/media/f5f4f3_29ea58ba046b45eca7c410096c8b2dc2~mv2.jpg/v1/fill/w_940,h_398,fp_0.46_0.32,q_90,usm_5.80_0.74_0.17,enc_avif,quality_auto/f5f4f3_29ea58ba046b45eca7c410096c8b2dc2~mv2.jpg)
![IMG_20211203_132731[1].jpg](https://static.wixstatic.com/media/f5f4f3_532591f168f44f66bec3f53ea9b3935a~mv2.jpg/v1/fill/w_940,h_398,fp_0.5_0.28,q_90,usm_5.80_0.74_0.17,enc_avif,quality_auto/f5f4f3_532591f168f44f66bec3f53ea9b3935a~mv2.jpg)
![IMG_20211203_132913[1].jpg](https://static.wixstatic.com/media/f5f4f3_9ccc7a46659a4c06aa5af0290c6e8aab~mv2.jpg/v1/fill/w_940,h_398,fp_0.46_0.25,q_90,enc_avif,quality_auto/f5f4f3_9ccc7a46659a4c06aa5af0290c6e8aab~mv2.jpg)
![IMG_20211203_133143[1].jpg](https://static.wixstatic.com/media/f5f4f3_d14c5dbefe5544d0b58c1dc9ae19bbcf~mv2.jpg/v1/fill/w_940,h_398,fp_0.4_0.29,q_90,enc_avif,quality_auto/f5f4f3_d14c5dbefe5544d0b58c1dc9ae19bbcf~mv2.jpg)
![IMG_20211203_133951[1].jpg](https://static.wixstatic.com/media/f5f4f3_0c92733cece54808ba7fece22ab5d634~mv2.jpg/v1/fill/w_940,h_398,fp_0.51_0.28,q_90,enc_avif,quality_auto/f5f4f3_0c92733cece54808ba7fece22ab5d634~mv2.jpg)
![IMG_20211203_134134[1].jpg](https://static.wixstatic.com/media/f5f4f3_3694c44ead4c44978869f5f7a239db0b~mv2.jpg/v1/fill/w_940,h_398,fp_0.54_0.29,q_90,usm_5.80_0.74_0.17,enc_avif,quality_auto/f5f4f3_3694c44ead4c44978869f5f7a239db0b~mv2.jpg)
![IMG_20211203_134251[1].jpg](https://static.wixstatic.com/media/f5f4f3_2570b0d2687c430ea7978a65c6ec0ba9~mv2.jpg/v1/fill/w_940,h_398,fp_0.46_0.41,q_90,enc_avif,quality_auto/f5f4f3_2570b0d2687c430ea7978a65c6ec0ba9~mv2.jpg)
![IMG_20211203_134439[1].jpg](https://static.wixstatic.com/media/f5f4f3_20c9df09bb57476e96a8bd5ee6856280~mv2.jpg/v1/fill/w_940,h_398,fp_0.51_0.43,q_90,enc_avif,quality_auto/f5f4f3_20c9df09bb57476e96a8bd5ee6856280~mv2.jpg)
![IMG_20211203_134614[1].jpg](https://static.wixstatic.com/media/f5f4f3_32b21468a4bb4aa3adec225a11760dac~mv2.jpg/v1/fill/w_940,h_398,fp_0.53_0.25,q_90,usm_5.80_0.74_0.17,enc_avif,quality_auto/f5f4f3_32b21468a4bb4aa3adec225a11760dac~mv2.jpg)
![IMG_20211203_135700[1].jpg](https://static.wixstatic.com/media/f5f4f3_99377908021b4b12a6691c63ab4ec9a5~mv2.jpg/v1/fill/w_940,h_398,fp_0.51_0.42,q_90,usm_5.80_0.74_0.17,enc_avif,quality_auto/f5f4f3_99377908021b4b12a6691c63ab4ec9a5~mv2.jpg)































































